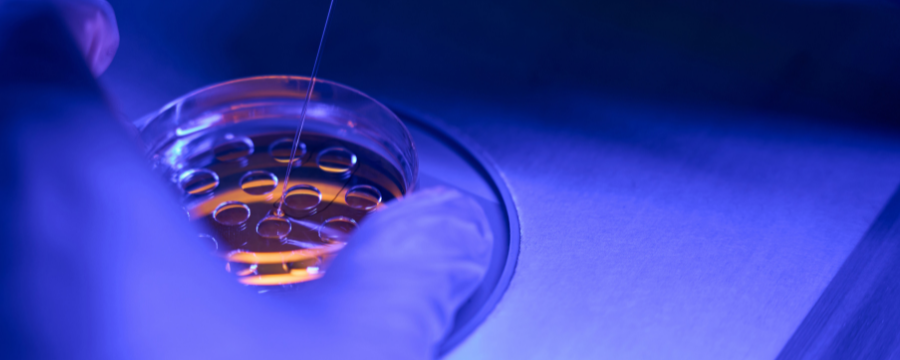
transferencia embriones

transferencia de embriones
¿Qué es la transferencia de embriones?
La transferencia de embriones es un procedimiento muy habitual en medicina reproductiva, ya que ayuda a aquellas parejas que están intentando tener hijos, y que no lo están logrando, a poder concebir. El proceso es el siguiente: se fertilizan los embriones que serán colocados dentro del útero de la mujer esperando a que se implanten.
Generalmente, la transferencia de embriones requiere de un tratamiento previo para la madre para garantizar el éxito de este proceso. Cuando se realiza la transferencia, conviene dejar claro que no duele y no necesita ningún tipo de anestesia. Por lo tanto, por esta parte, las mujeres que se sometan a este procedimiento pueden estar tranquilas.

La transferencia de embriones consta de:
- Preparación del útero: con la toma de fármacos que contienen hormonas se busca que la capa interna del útero se vuelva más gruesa y receptiva para que el óvulo fecundado se implante exitosamente en él.
- Fertilización in vitro: los óvulos son fecundados en el laboratorio, fuera del cuerpo de la mujer. Además, se observan detenidamente para determinar cuáles tienen un mayor potencial para implantarse con éxito.
- Proceso de transferencia: el médico encargado de este procedimiento emplea un catéter muy delgado con el que introducirá los embriones en el útero de la mujer, a través del cuello uterino. No duele, aunque puede ser algo molesto.
Después de que se complete la transferencia de embriones se le hará un seguimiento a la mujer. En algunos casos, puede recomendársele que durante los primeros días, en los que se implantará el óvulo, descanse y mantenga reposo para facilitar que esto ocurra. Días o semanas después, se realizará una prueba de embarazo para verificar que la transferencia embrionaria ha tenido éxito o no.
